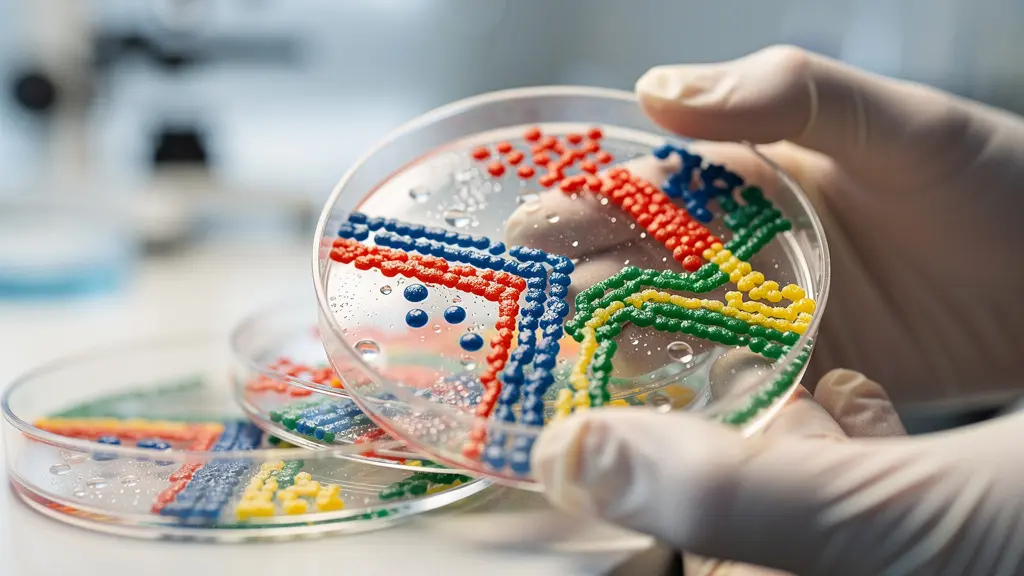
Forschungskooperation zwischen ETH und EPFL im Biotech-Labor

Entgegen der verbreiteten Annahme sind die hohen Bruttolöhne in der Schweiz kein Nachteil, sondern ein Indikator für ein hocheffizientes Ökosystem, das die Gesamtbetriebskosten (Total Cost of Ownership) senkt.
- Die Lohnnebenkosten für Arbeitgeber sind signifikant niedriger als in Deutschland oder Frankreich, was die Gesamtkosten relativiert.
- Ein flexibles Arbeitsrecht und eine überlegene Logistikinfrastruktur minimieren operative Reibungsverluste und versteckte Kosten.
Empfehlung: Analysieren Sie nicht nur die Lohn- und Steuerquoten, sondern bewerten Sie das gesamte Produktivitäts-Ökosystem, um die wahre Rentabilität des Standorts Schweiz zu erfassen.
Für einen internationalen Manager oder Investor, der Expansionsmöglichkeiten prüft, scheint die Schweiz auf den ersten Blick ein kostspieliges Paradoxon zu sein. Die Schlagzeilen über die weltweit höchsten Durchschnittslöhne können abschreckend wirken und den Anschein erwecken, dass die Betriebskosten untragbar hoch sind. Viele Analysen bleiben bei oberflächlichen Vergleichen von Steuersätzen und Lebenshaltungskosten stehen und bestätigen damit das Bild eines teuren, wenn auch stabilen Standorts. Diese Perspektive ist jedoch trügerisch, denn sie ignoriert den entscheidenden Faktor für eine fundierte Standortentscheidung: die Gesamtbetriebskosten (Total Cost of Ownership, TCO).
Die wahre Attraktivität der Schweiz, insbesondere für wissensintensive Branchen wie die Biotechnologie, liegt nicht in einzelnen isolierten Vorteilen. Sie wurzelt in einem fein abgestimmten Produktivitäts-Ökosystem, in dem höhere Löhne durch eine ausserordentliche Effizienz, geringere administrative Hürden und eine beispiellose Innovationskraft mehr als kompensiert werden. Wer nur auf die Bruttolohnsumme blickt, übersieht die versteckten Kosten, die in anderen Ländern durch starre Arbeitsmärkte, ineffiziente Logistik oder eine grössere Distanz zwischen Forschung und Anwendung entstehen.
Dieser Artikel bricht mit der traditionellen Sichtweise. Statt die üblichen Vorteile aufzuzählen, dekonstruieren wir die Gesamtbetriebskosten für ein Biotech-Unternehmen in der Schweiz. Wir analysieren, warum das scheinbar teuerste Element – das Personal – bei einer ganzheitlichen Betrachtung Teil einer Gleichung ist, die zu höherer Rentabilität und nachhaltigem Wachstum führt. Es ist an der Zeit, den Fokus von den Kosten pro Mitarbeiter auf den Ertrag pro investiertem Franken zu verlagern.
Die folgende Analyse führt Sie durch die entscheidenden Faktoren, die das Schweizer Modell so erfolgreich machen. Jeder Abschnitt beleuchtet eine Facette des Ökosystems und zeigt auf, wie sie zur Optimierung Ihrer Gesamtbetriebskosten beiträgt.
Inhaltsverzeichnis: Die Standortanalyse Schweiz für Biotech-Unternehmen
- Warum ist das Schweizer Kündigungsrecht flexibler als in Frankreich oder Deutschland?
- Wie profitiert mein Unternehmen von der Nähe zur ETH und EPFL?
- Schiene oder Strasse: Was macht die Schweizer Logistik trotz LSVA effizient?
- Der Fehler, nur die Bruttolöhne zu vergleichen und die tiefen Sozialabgaben zu ignorieren
- Wann wird der Marktzugang zur EU für Schweizer Exporteure kritisch?
- Niedrige Steuern oder günstige Mieten: Was wiegt für ein Start-up schwerer?
- Warum verdienen zweisprachige Kader in Bern oft mehr als ihre einsprachigen Kollegen?
- Wie profitieren Neuunternehmen von Steuererleichterungen in Randregionen?
Warum ist das Schweizer Kündigungsrecht flexibler als in Frankreich oder Deutschland?
Die Flexibilität des Arbeitsmarktes ist ein oft unterschätzter, aber fundamentaler Baustein des Schweizer Erfolgsmodells. Während in Nachbarländern wie Deutschland oder Frankreich ein rigider Kündigungsschutz die unternehmerische Agilität einschränkt, bietet die Schweiz eine sogenannte „Flexibilitätsprämie“. Diese resultiert aus dem Grundsatz der Kündigungsfreiheit, der es Unternehmen ermöglicht, schnell auf Marktveränderungen zu reagieren, Personal umzuschichten oder strategische Neuausrichtungen ohne langwierige und kostspielige Verfahren umzusetzen. Diese administrative Schlankheit reduziert die versteckten Kosten, die durch Bürokratie und Rechtsstreitigkeiten entstehen.
In Deutschland beispielsweise erfordert eine Kündigung einen sozial gerechtfertigten Grund und muss strengen formellen Kriterien genügen. In Frankreich sind die Verfahren ebenfalls stark reglementiert und oft mit hohen Abfindungen verbunden. Im Gegensatz dazu ist im Schweizer Obligationenrecht (OR) die Kündigung grundsätzlich formfrei – sie kann sogar mündlich ausgesprochen werden – und bedarf keiner Begründung. Dies schafft eine Umgebung, in der die Personalplanung ein strategisches Werkzeug bleibt und nicht zu einem administrativen Hindernis wird. Für ein Biotech-Unternehmen, dessen Erfolg von schnellen Innovationszyklen und der Fähigkeit zur Anpassung an Forschungsergebnisse abhängt, ist dieser Unterschied geschäftskritisch.
Der folgende Vergleich macht deutlich, wie sich die gesetzlichen Rahmenbedingungen direkt auf die operative Planung auswirken, wie eine aktuelle Analyse der arbeitsrechtlichen Unterschiede zeigt. Die kürzeren Fristen und der Wegfall der Begründungspflicht in der Schweiz senken die Transaktionskosten bei Personalentscheidungen erheblich.
| Land | 1. Dienstjahr | 2-9. Dienstjahr | Ab 10. Dienstjahr | Kündigungsgrund erforderlich |
|---|---|---|---|---|
| Schweiz | 1 Monat | 2 Monate | 3 Monate | Nein (Kündigungsfreiheit) |
| Deutschland | 4 Wochen | 1-3 Monate | 4-7 Monate | Ja (Kündigungsschutzgesetz) |
| Frankreich | 1-2 Monate | 2 Monate | 3 Monate | Ja (licenciement pour faute) |
Diese strukturelle Flexibilität ist kein Freibrief für Willkür, sondern die Grundlage für eine dynamische Wirtschaft. Sie ermöglicht es Unternehmen, in Phasen des Wachstums schnell hochqualifizierte Talente einzustellen und in Konsolidierungsphasen ebenso agil zu reagieren. Für einen Investor bedeutet dies ein geringeres Risiko und eine höhere Kapitalrendite, da das Unternehmen effizienter auf die Unwägbarkeiten des Marktes reagieren kann.
Wie profitiert mein Unternehmen von der Nähe zur ETH und EPFL?
Die Präsenz von Weltklasse-Universitäten wie der ETH Zürich und der EPFL in Lausanne ist weit mehr als ein Prestigefaktor. Für Biotech-Unternehmen stellt diese Nähe eine direkte Quelle für eine messbare „Innovationsrendite“ dar. Es geht nicht nur um den Zugang zu einem Pool hochqualifizierter Absolventen, sondern um die nahtlose Integration in ein Ökosystem, das den Transfer von Grundlagenforschung in kommerziell nutzbare Anwendungen aktiv fördert und beschleunigt. Dies verkürzt die Zeit von der Entdeckung bis zur Marktreife und maximiert den Return on Investment in Forschung und Entwicklung (F&E).
Die Universitäten agieren als Katalysatoren für die Gründung von Spin-offs und die Entwicklung neuer Technologien, die direkt von etablierten Unternehmen lizenziert oder in Kooperationen weiterentwickelt werden können. Die physische Nähe erleichtert den informellen Austausch, die gemeinsame Nutzung von teuren Laborinfrastrukturen und die Rekrutierung von Talenten, die bereits mit den neuesten wissenschaftlichen Methoden vertraut sind. Eine aktuelle Analyse zu Universitäts-Ausgründungen bestätigt die finanzielle Potenz dieses Ökosystems: Im Jahr 2024 wurden 710 Millionen CHF von Schweizer Universitäts-Spin-offs aufgenommen, davon allein 425 Millionen CHF von ETH-Zürich-Unternehmen. Diese Zahlen belegen, dass die wissenschaftliche Exzellenz direkt in wirtschaftlichen Wert umgewandelt wird.
Wie diese Abbildung einer Forschungskooperation andeutet, ist die Zusammenarbeit zwischen Akademie und Industrie in der Schweiz keine theoretische, sondern eine gelebte Praxis. Die Durchlässigkeit zwischen den Institutionen schafft einen kontinuierlichen Fluss von Wissen, Talenten und Kapital. Für ein in der Schweiz ansässiges Biotech-Unternehmen bedeutet dies einen unschätzbaren Wettbewerbsvorteil: den direkten Zugang zu den Ideen und Menschen, die die Zukunft der Branche gestalten. Dieser Vorteil ist in einer reinen Kostenrechnung schwer zu quantifizieren, aber für den langfristigen Erfolg von entscheidender Bedeutung.
Schiene oder Strasse: Was macht die Schweizer Logistik trotz LSVA effizient?
Eine effiziente, zuverlässige und temperaturkontrollierte Logistik ist für die Biotech-Branche nicht verhandelbar. Produkte im Wert von Millionen können durch eine einzige Unterbrechung der Kühlkette wertlos werden. Auf den ersten Blick könnte die Leistungsabhängige Schwerverkehrsabgabe (LSVA) in der Schweiz als Kostentreiber erscheinen. Bei einer Analyse der Gesamtbetriebskosten entpuppt sie sich jedoch als cleveres Steuerungsinstrument, das ein hochmodernes und äusserst zuverlässiges Logistiksystem finanziert. Die LSVA fördert den Schienenverkehr und sichert gleichzeitig die Finanzierung für eine Strasseninfrastruktur von höchster Qualität.
Das Ergebnis ist ein intermodales System, das seinesgleichen sucht. Die NEAT-Achse mit dem Gotthard- und Lötschberg-Basistunnel ermöglicht schnelle und zuverlässige Schienentransporte durch die Alpen, was besonders für temperaturgeführte Fracht von entscheidender Bedeutung ist. An den Endpunkten dieser Achsen sorgen intermodale Containerterminals für einen nahtlosen Übergang auf die Strasse für die „letzte Meile“. Diese Effizienz minimiert das Risiko von Verzögerungen und Qualitätsproblemen – beides sind erhebliche versteckte Kosten in der Lieferkette.
Zusätzlich garantieren spezialisierte Infrastrukturen wie die GDP-zertifizierten Pharma-Hubs an den Flughäfen Zürich, Genf und Basel die Einhaltung der „Good Distribution Practice“. In Kombination mit einer 24/7-Zollabfertigung für zeitkritische Produkte entsteht ein Logistik-Ökosystem, das auf die Bedürfnisse der Life-Sciences-Industrie perfekt zugeschnitten ist. Die durch die LSVA finanzierten Investitionen sind somit keine Belastung, sondern eine Versicherung für die Integrität der Lieferkette.
Audit-Checkliste: Effizienz der Schweizer Pharma-Logistik
- Punkte-Kontakt: Prüfen Sie die Anbindung Ihrer Standorte an die NEAT-Achse für transeuropäische Transporte.
- Collecte: Inventarisieren Sie die Verfügbarkeit von GDP-zertifizierten Logistikpartnern und Hubs in Ihrer Region (Zürich, Genf, Basel).
- Kohärenz: Bewerten Sie, wie nahtlos der Übergang zwischen Schiene und Strasse (intermodale Terminals) für Ihre Lieferkette funktioniert.
- Mémorabilité/Émotion: Analysieren Sie die Zuverlässigkeit (Pünktlichkeit, Einhaltung der Temperatur) im Vergleich zu rein strassenbasierten Routen in anderen Ländern.
- Plan d’intégration: Entwickeln Sie eine Logistikstrategie, die gezielt die Vorteile des Schienenverkehrs zur Risikominimierung und Kostensenkung nutzt.
Für einen Investor bedeutet dies, dass die Schweiz nicht nur einen Produktions-, sondern auch einen hochsicheren Distributionsstandort darstellt. Die höheren direkten Transportkosten durch die LSVA werden durch eine drastisch reduzierte Rate an Produktverlusten und eine höhere Planungssicherheit mehr als aufgewogen.
Der Fehler, nur die Bruttolöhne zu vergleichen und die tiefen Sozialabgaben zu ignorieren
Dies ist der Kernpunkt, an dem die oberflächliche Analyse der Standortkosten scheitert. Ein direkter Vergleich der Bruttogehälter zwischen der Schweiz und Ländern wie Deutschland oder Frankreich ist irreführend und führt zu falschen Schlussfolgerungen. Der entscheidende Faktor für die Personal-Gesamtkosten eines Unternehmens sind nicht die Bruttolöhne, sondern die gesamten Arbeitgeberkosten. Und hier offenbart das Schweizer System seinen grössten, oft verborgenen Vorteil: die vergleichsweise niedrigen Lohnnebenkosten.
Während in Deutschland die Sozialversicherungsbeiträge für den Arbeitgeber rund 20 % des Bruttogehalts ausmachen, liegen die obligatorischen Beiträge in der Schweiz (AHV/IV/EO/ALV) deutlich darunter. Selbst unter Einbezug der Beiträge zur beruflichen Vorsorge (Pensionskasse), die je nach Plan variieren, bleiben die Gesamtbelastungen für den Arbeitgeber oft signifikant niedriger. Ein hoher Bruttolohn in der Schweiz bedeutet also nicht zwangsläufig höhere Gesamtkosten für das Unternehmen. Vielmehr kommt ein grösserer Teil des Geldes direkt beim Arbeitnehmer an, was die Schweiz als Arbeitsort attraktiver macht und die Mitarbeiterbindung stärkt – ein weiterer Faktor, der die Kosten für Rekrutierung und Einarbeitung senkt.

Die folgende Tabelle, die auf verfügbaren Vergleichsdaten basiert, illustriert diesen Punkt anhand eines Beispiels für eine hochqualifizierte Fachkraft. Sie zeigt, dass die Differenz der Gesamtkosten für den Arbeitgeber weitaus geringer ist, als es der Vergleich der Bruttogehälter vermuten lässt. Die wahren Kosten liegen näher beieinander, während der Nettovorteil für den Mitarbeiter in der Schweiz bestehen bleibt.
| Kostenposition | Schweiz (CHF) | Deutschland (EUR) |
|---|---|---|
| Bruttogehalt | 150’000 | 110’000 |
| AHV/IV/EO/ALV (ca. 7%) | 10’500 | – |
| Pensionskasse (ca. 12%) | 18’000 | – |
| Sozialversicherung DE (ca. 20%) | – | 22’000 |
| Total Arbeitgeberkosten | 178’500 | 132’000 |
| Umgerechnet (1 CHF = 1.05 EUR) | 187’425 EUR | 132’000 EUR |
Diese Analyse der Gesamtbetriebskosten kehrt das ursprüngliche Narrativ um. Die hohen Bruttolöhne sind kein Hindernis, sondern Teil eines effizienten Systems, das hochqualifizierte Talente anzieht und gleichzeitig die Belastung für Unternehmen in einem international wettbewerbsfähigen Rahmen hält.
Wann wird der Marktzugang zur EU für Schweizer Exporteure kritisch?
Der privilegierte Zugang zum europäischen Binnenmarkt ist für die exportorientierte Schweizer Biotech-Industrie von existenzieller Bedeutung. Dieser Zugang ist jedoch keine Selbstverständlichkeit, sondern hängt von einem komplexen Geflecht bilateraler Abkommen ab. Für Biotech-Unternehmen ist insbesondere das Mutual Recognition Agreement (MRA) von entscheidender Wichtigkeit. Es sorgt dafür, dass Konformitätsprüfungen und Zertifizierungen von Produkten, die in der Schweiz durchgeführt werden, in der EU anerkannt werden – und umgekehrt. Ein Wegfall oder eine Nichterneuerung dieses Abkommens würde zu einem massiven Anstieg der Betriebskosten führen.
Ohne ein aktualisiertes MRA müssten Schweizer Hersteller ihre Produkte für den EU-Markt ein zweites Mal zertifizieren lassen. Dies würde nicht nur zu direkten Mehrkosten führen, sondern auch zu erheblichen Zeitverzögerungen bei der Markteinführung neuer Medikamente oder Medizinprodukte. In einer schnelllebigen Branche wie der Biotechnologie können solche Verzögerungen den gesamten Business Case eines Produkts gefährden. Die politische Unsicherheit bezüglich des bilateralen Wegs stellt daher das grösste externe Risiko für in der Schweiz ansässige Unternehmen dar.
Die Dimension dieses Risikos wird deutlich, wenn man die wirtschaftliche Bedeutung der Branche betrachtet. Laut dem Swiss Biotech Report 2025 entfielen 52 % des gesamten Schweizer Aussenhandels (283 Milliarden CHF) im Jahr 2024 auf die Chemie-, Pharma- und Life-Sciences-Branchen. Ein Grossteil davon geht in die EU. Jede Störung dieses Handelsflusses hätte unmittelbare und gravierende Auswirkungen. Die Schweizer Pharmaindustrie beobachtet daher die politischen Diskussionen mit grosser Sorge. Themen wie US-Zölle, die OECD-Mindestbesteuerung und insbesondere der offene Ausgang des bilateralen Wegs stehen im Fokus. Ein stabiler und verlässlicher Marktzugang bleibt die Grundvoraussetzung für den Erfolg des Standorts.
Für Investoren bedeutet dies, dass die politische Entwicklung und die Stabilität der Beziehungen zwischen der Schweiz und der EU ein zentraler Faktor in der Risikobewertung sein müssen. Auch wenn das operative Umfeld exzellent ist, hängt die langfristige Rentabilität entscheidend von der Aufrechterhaltung der bilateralen Verträge ab.
Niedrige Steuern oder günstige Mieten: Was wiegt für ein Start-up schwerer?
Für ein junges Biotech-Start-up ist die Standortfrage oft eine Abwägung zwischen zwei wesentlichen Kostenblöcken: den Steuern und den Mietkosten für Labor- und Büroflächen. Die Antwort darauf, was schwerer wiegt, ist jedoch nicht statisch. Sie hängt entscheidend von der Phase im Lebenszyklus des Unternehmens ab. Eine intelligente Standortstrategie ist dynamisch und passt die Prioritäten an die jeweilige Entwicklungsstufe an.
In der Pre-Seed- und Seed-Phase, in der das Unternehmen noch keine Gewinne macht, ist der Steuersatz irrelevant. Hier hat die Minimierung der Fixkosten oberste Priorität. Günstige Mieten in Technologieparks wie dem Bio-Ark in Visp oder dem Technopark Zürich sind entscheidend, um die „Burn Rate“ niedrig zu halten und das Kapital für die eigentliche Forschung zu verwenden. In dieser Phase ist auch die Nähe zu Universitäten und potenziellen ersten Kooperationspartnern wichtiger als die Steueroptimierung.
Sobald das Unternehmen in die Wachstums- und Scale-up-Phase eintritt und erste Gewinne erzielt, verschiebt sich die Gewichtung. Der kantonale Steuersatz wird nun zu einem kritischen Faktor, da er direkt beeinflusst, wie viel Kapital für die Reinvestition in weiteres Wachstum zur Verfügung steht. Standorte in Tiefsteuerkantonen wie Zug werden attraktiver. Gleichzeitig wird die Nähe zu Venture-Capital-Gebern und einem internationalen Talentpool, wie er in der Genfersee-Region oder im Raum Zug zu finden ist, geschäftskritisch. Die erfolgreichsten Start-up-Ökosysteme bieten eine Balance aus beidem. Eine Analyse der Schweizer Startup-Landschaft zeigt, dass obwohl Universitäts-Spin-offs nur 0.15% aller neuen Unternehmen ausmachen, sie aber 25% aller Startup-Finanzierungsrunden erhalten, was die Bedeutung des Ökosystems unterstreicht.
Die optimale Strategie besteht also nicht in einer einmaligen Entscheidung, sondern in einer lebenszyklus-basierten Planung. Viele erfolgreiche Unternehmen starten in einem innovationsnahen, mietgünstigen Umfeld und verlagern später ihren juristischen Sitz zur Steueroptimierung, während die F&E-Aktivitäten am ursprünglichen Ort verbleiben. Diese Flexibilität ist eine der grossen Stärken des föderalen Schweizer Systems.
Warum verdienen zweisprachige Kader in Bern oft mehr als ihre einsprachigen Kollegen?
Die Tatsache, dass zweisprachige Führungskräfte, insbesondere in einer Brückenstadt wie Bern, oft ein höheres Gehalt erzielen, ist kein Zufall, sondern ein direktes Spiegelbild des Schweizer Wirtschaftsmodells. Im Kontext der Biotech-Branche ist Mehrsprachigkeit (typischerweise Deutsch/Französisch und Englisch) keine „Soft Skill“, sondern eine harte Kernkompetenz, die Reibungsverluste im nationalen und internationalen Geschäft minimiert. Die Schweiz ist ein mehrsprachiges Land mit drei grossen Wirtschaftsräumen. Eine Führungskraft, die nahtlos zwischen diesen Kulturen und Sprachen navigieren kann, steigert die Effizienz des gesamten Unternehmens.
In der stark regulierten Gesundheits- und Pharmaindustrie ist die präzise Kommunikation mit Behörden wie Swissmedic, aber auch mit Partnern, Lieferanten und Kunden in den verschiedenen Landesteilen, geschäftskritisch. Missverständnisse können zu kostspieligen Verzögerungen führen. Ein zweisprachiger Manager kann die Koordination zwischen einem F&E-Standort in der Deutschschweiz und einer Produktionsstätte in der Romandie erheblich beschleunigen. Diese Fähigkeit, als Brückenbauer zu fungieren, ist ein direkter Beitrag zur Senkung der operativen Kosten und zur Steigerung der Produktivität.
Fallbeispiel: Die Rolle der Mehrsprachigkeit im Schweizer Biotech-Sektor
Wissenschaftler und Manager mit multinationalen Hintergründen und Studienerfahrungen sind ein Eckpfeiler des Schweizer Erfolgs. Ihre Fähigkeit, zwischen verschiedenen Sprachregionen und Geschäftskulturen zu vermitteln, ist besonders im regulierten Gesundheitswesen von unschätzbarem Wert. Sie ermöglichen nicht nur die interne Kohäsion, sondern sind auch entscheidend für die internationale Vernetzung und die Anbahnung von globalen Partnerschaften, was den Wert des Unternehmens direkt steigert.
Der Gehaltsaufschlag für Zweisprachigkeit ist somit keine Prämie für eine nette Zusatzqualifikation, sondern die marktwirtschaftliche Bewertung einer Fähigkeit, die die Effizienz steigert und Risiken minimiert. Für ein Unternehmen, das in der gesamten Schweiz und international tätig ist, ist die Investition in mehrsprachige Führungskräfte eine Investition in die reibungslose Funktion des eigenen Betriebs. Es ist ein klassisches Beispiel dafür, wie ein höherer Lohn zu niedrigeren Gesamtbetriebskosten führen kann.
Das Wichtigste in Kürze
- Die Gesamtbetriebskosten (TCO) sind der entscheidende Massstab, nicht die Bruttolöhne allein.
- Niedrigere Lohnnebenkosten in der Schweiz relativieren die hohen Bruttogehälter im Vergleich zu Deutschland oder Frankreich.
- Ein flexibles Arbeitsrecht und eine hochmoderne Logistikinfrastruktur minimieren operative Kosten und Geschäftsrisiken.
Wie profitieren Neuunternehmen von Steuererleichterungen in Randregionen?
Die föderale Struktur der Schweiz führt zu einem intensiven Standortwettbewerb zwischen den Kantonen, von dem insbesondere Neuunternehmen profitieren können. Während Metropolregionen wie Zürich oder Genf mit ihrer Nähe zu Kapital und internationalen Flughäfen punkten, haben sich viele Randregionen strategisch positioniert, um gezielt wissensintensive Unternehmen anzuziehen. Ihr Hauptinstrument sind dabei signifikante Steuererleichterungen für Neugründungen und Unternehmen, die neue Arbeitsplätze schaffen.
Diese Steuerferien können für einen Zeitraum von bis zu zehn Jahren gewährt werden und umfassen oft sowohl die kantonalen als auch die kommunalen Steuern. Für ein Biotech-Unternehmen, das nach einer langen und kapitalintensiven F&E-Phase in die Gewinnzone kommt, kann dies einen massiven Unterschied ausmachen. Das eingesparte Kapital kann direkt in die Expansion, das Marketing oder weitere Forschung reinvestiert werden, was einen erheblichen Wachstumsschub ermöglicht. Diese Strategie ist keine blosse Subvention, sondern eine gezielte Investition der Regionen in den Aufbau zukunftsfähiger Wirtschaftscluster.
Ein herausragendes Beispiel für den Erfolg dieses Modells ist der Bio-Technopark in Schlieren bei Zürich. Obwohl nicht in einer klassischen Randregion gelegen, zeigt das Modell, wie gezielte Förderung und die Schaffung eines Ökosystems funktionieren. Im Park haben sich rund 25 kleine Firmen angesiedelt. Ein Paradebeispiel ist Molecular Partners, ein Unternehmen, das im Park gross wurde und im November 2014 erfolgreich an die Schweizer Börse ging, wobei es über hundert Millionen Franken Kapital aufnahm. Dies zeigt, wie Standorte ausserhalb der grossen Zentren durch eine kluge Kombination aus steuerlichen Anreizen und spezialisierter Infrastruktur zu Brutstätten für hochinnovative und erfolgreiche Unternehmen werden können.
Für ein Neuunternehmen bedeutet dies, dass die Standortwahl eine strategische Entscheidung ist, die weit über die reine Adressangabe hinausgeht. Durch die Wahl einer Förderregion können die Weichen für ein beschleunigtes und finanziell nachhaltiges Wachstum gestellt werden.
Die Entscheidung für den Standort Schweiz ist somit keine, die auf einer einzelnen Kennzahl beruht. Sie ist das Ergebnis einer umfassenden Analyse der Gesamtbetriebskosten, bei der die scheinbaren Nachteile durch ein hocheffizientes und synergetisches Ökosystem mehr als kompensiert werden. Für Ihr Unternehmen ist die Analyse der Gesamtbetriebskosten der entscheidende erste Schritt. Beginnen Sie jetzt mit einer fundierten Bewertung, um die wahren Vorteile des Standorts Schweiz zu quantifizieren.